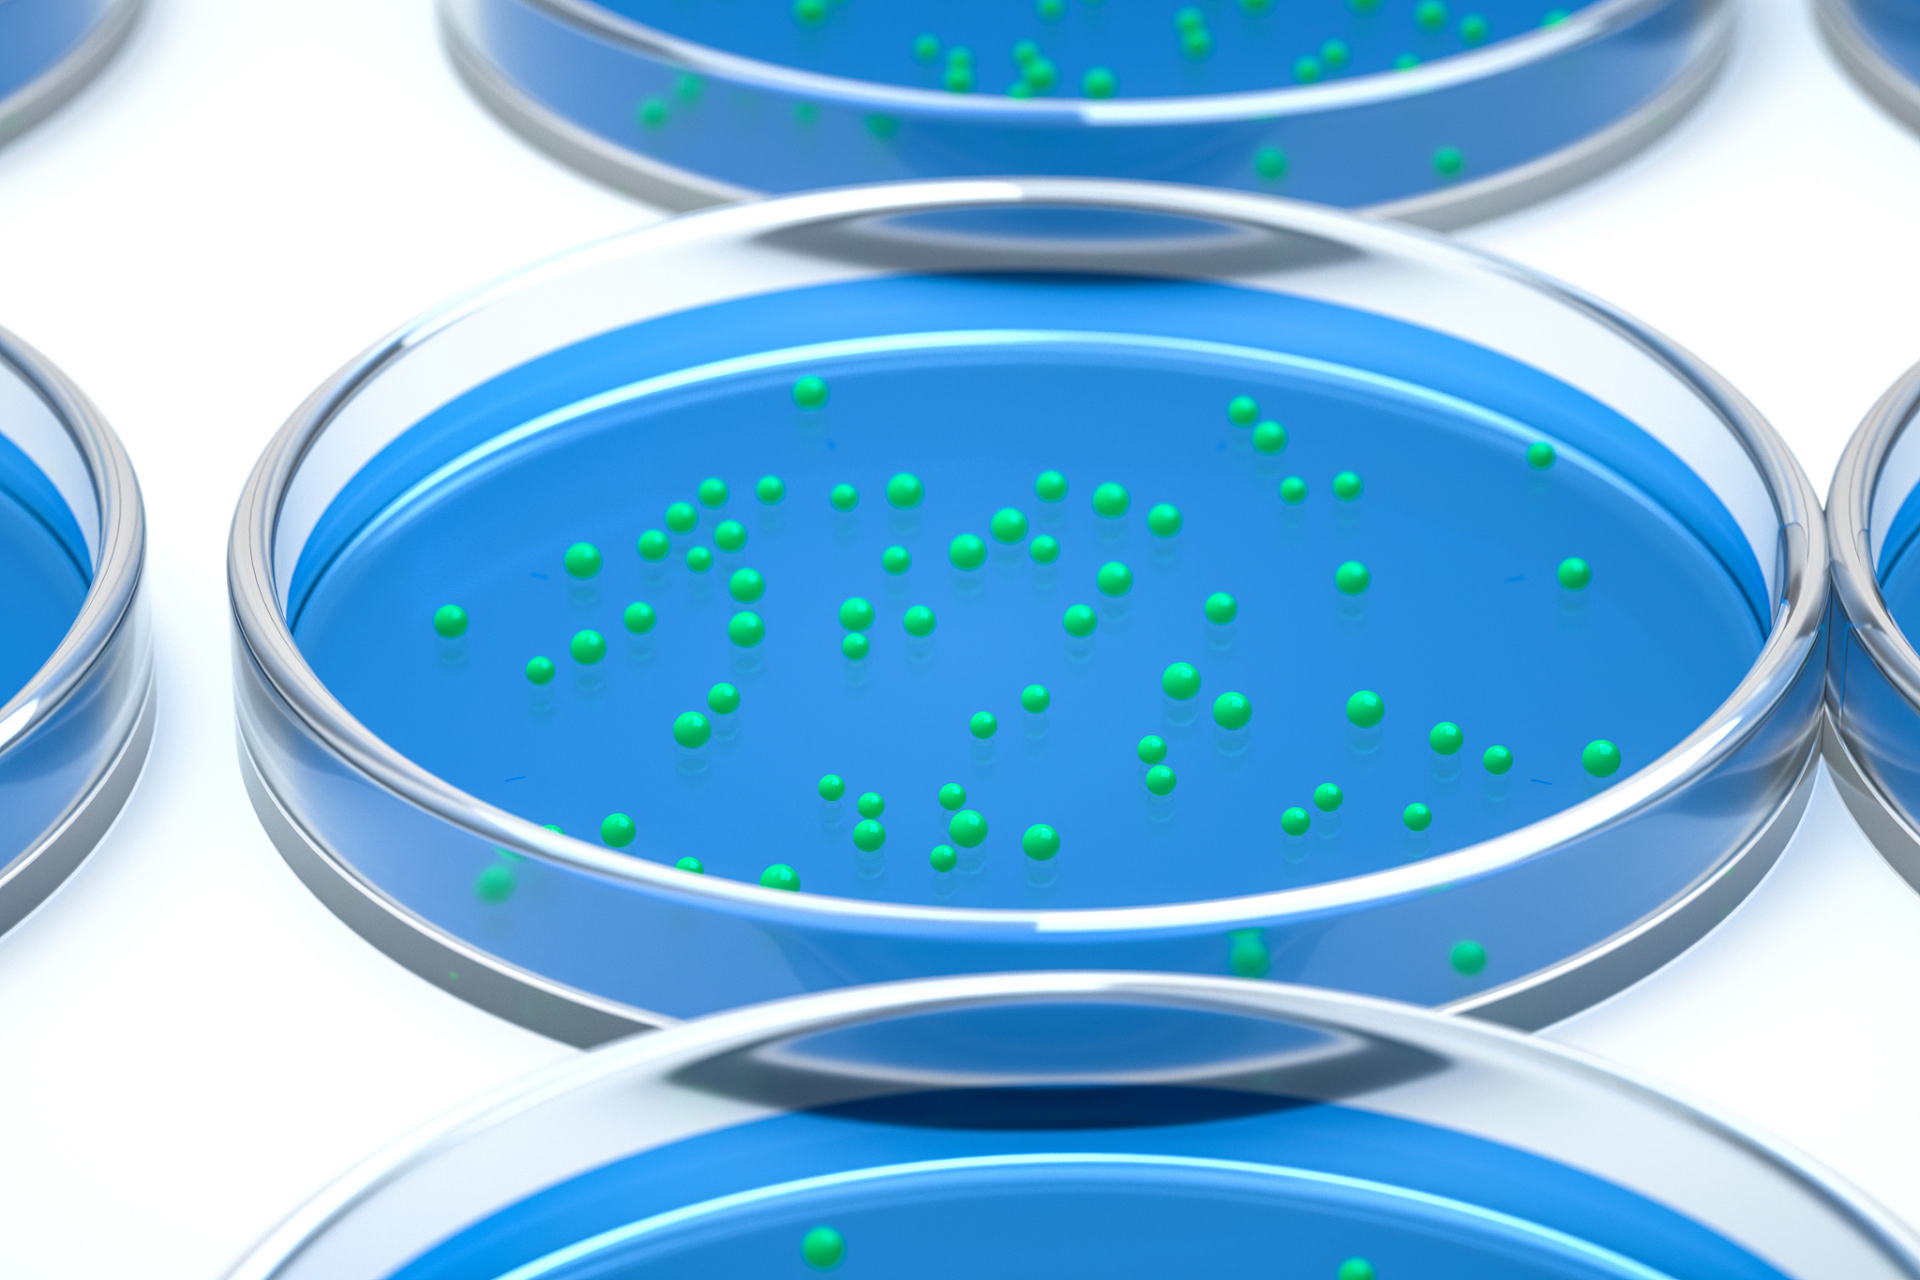
有两种方法进行原代细胞的传代培养:贴壁细胞的消化法和悬浮细胞的传

原代细胞

神经元细胞原代细胞
图片尺寸1080x810
原代细胞
图片尺寸600x600
新生大鼠原代小胶质细胞形态在加lps激活前后都会出现阿米巴状无法分
图片尺寸600x703
原代小胶质细胞培养经验
图片尺寸2049x1537
浅谈原代细胞永生化
图片尺寸900x527
原代细胞/干细胞分离培养及鉴定检测实验外包服务
图片尺寸2362x2109
鸡胚细胞原代培养,请大家帮我看看细胞怎么成这个样子了?
图片尺寸2634x1784
有两种方法进行原代细胞的传代培养:贴壁细胞的消化法和悬浮细胞的传
图片尺寸1920x1280
小鼠原代肝细胞pmh
图片尺寸2748x2200
【主题学习】肝星状细胞原代培养方法及trouble-shooting
图片尺寸1600x1200
原代细胞培养攻略,学会正确操作,成功培养高质量细胞_细胞培养有秘招
图片尺寸2592x1944
技术分享云克隆原代细胞
图片尺寸579x321
大鼠原代心肌细胞
图片尺寸1080x804
技术分享云克隆原代细胞
图片尺寸589x331
原代小胶质细胞培养经验
图片尺寸2049x1537
sd大鼠海马神经元原代细胞培养
图片尺寸1536x2048
67原代细胞培养基础知识汇总
图片尺寸1080x581
人子宫内膜基质细胞
图片尺寸400x262
原代牙周膜干细胞
图片尺寸1080x720
原代小胶质细胞
图片尺寸640x853